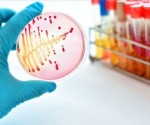
neumonía-virus-580x373

El autismo primario consiste en un trastorno del neurodesarrollo de etiología inespecífica, cuya base genética aún no está esclarecida totalmente. Se caracteriza por una mayor incidencia en el sexo masculino, por ausenciade marcador biológico y, clínicamente, por deficiencias en la socialización, la comunicación verbal y no verbal, y patrones de comportamiento restringidos y repetitivos, que, […]
9 jun 21 - Noticia - 0Leer más
Cuando se detectó la enfermedad COVID-19 en el mundo las embarazadas no eran población de riesgo, pero hoy en día sí, dijo a Sputnik el ginecólogo y epidemiólogo uruguayo Claudio Sosa, por lo cual comenzó a recomendarse que se vacunaran. «Inicialmente cuando empezó la pandemia (las embarazadas) no eran población de riesgo, hoy en día […]
8 jun 21 - Noticia - 0Leer más
Dos gemelas idénticas que viven en la misma casa en Brasil contrajeron la COVID-19 y manifestaron síntomas leves, tales como fiebre, tos y congestión nasal, sin necesidad de internación hospitalaria. Cuatro meses después, en agosto de 2020, una de las hermanas se infectó nuevamente. Pero en esa ocasión desarrolló un cuadro más grave, con una […]
7 jun 21 - Noticia - 0Leer más
En México se detectó el primer caso de una persona infectada con mucormicosis, enfermedad conocida como “hongo negro”, en un paciente recuperado de COVID-19, según reportes médicos citados por el periódico El Universal. Esta dolencia poco frecuente y potencialmente mortal fue diagnosticada a miles de pacientes de la India, nación gravemente afectada por el coronavirus, […]
4 jun 21 - Noticia - 0Leer más